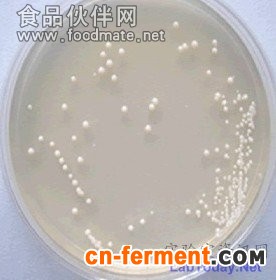
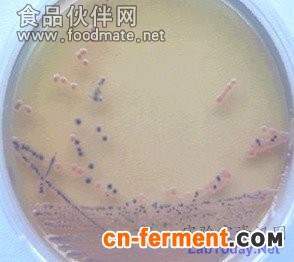

1、用固体培养基分离和纯化
单个微生物在适宜的固体培养基表面或内部生长、繁殖到一定程度可以形成肉眼可见的、有一定形态结构的子细胞生长群体,称为菌落。当固体培养基表面众多菌落连成一片时,便成为菌苔。不同微生物在特定培养基上生长形成的菌落或菌苔一般都具有稳定的特征,可以成为对该微生物进行分类、鉴定的重要依据。大多数细菌、酵母菌、以及许多真菌和单细胞藻类能在固体培养基上形成孤立的菌落,采用适宜的平板分离法很容易得到纯培养。所谓平板,即培养平板的简称,它是指固体培养基倒入无菌平皿,冷却凝固后,盛固体培养基的平皿。这方法包括将单个微生物分离和固定在固体培养基表面或里面。固体培养基用琼脂或其它凝胶物质固化的培养基,每个孤立的活微生物体生长、繁殖形成菌落,形成的菌落便于移植。最常用的分离、培养微生物的固体培养基是琼脂固体培养基平板。这种由Kock建立的采用平板分离微生物纯培养的技术简便易行,100多年来一直是各种菌种分离的最常用手段。
1.1 稀释倒平板法
首先把微生物悬液作一系列的稀释(如1:10、1:100、1:1000、1:10000),然后分别取不同稀释液少许,与已熔化并冷却至50℃左右的琼脂培养基混合,摇匀后,倾入灭过菌的培养皿中,待琼脂凝固后,制成可能含菌的琼脂平板,保温培养一定时间即可出现菌落。如果稀释得当,在平板表面或琼脂培养基中就可出现分散的单个菌落,这个菌落可能就是由一个细菌细胞繁殖形成的。随后挑取该单个菌落,或重复以上操作数次,便可得到纯培养。
1.2 涂布平板法
因为将微生物悬液先加到较烫的培养基中再倒平板易造成某些热敏感菌的死亡,且采用稀释倒平板法也会使一些严格好氧菌因被固定在琼脂中间缺乏氧气而影响其生长,因此在微生物学研究中常用的纯种分离方法是涂布平板法。其做法是先将已熔化的培养基倒入无菌平皿,制成无菌平板,冷却凝固后,将一定量的微生物悬液滴加在平板表面,再用无菌玻璃涂棒将菌液均匀分散至整个平板表面,经培养后挑取单个菌落(图1)。
图1 涂布平板法
1.3 平板划线法
最简单的分离微生物的方法是平板划线法,即用接种环以无菌操作沾取少许待分离的材料,在无菌平板表面进行连续划线(图2),微生物细胞数量将随着划线次数的增加而减少,并逐步分散开来,如果划线适宜的话,微生物能一一分散,经培养后,可在平板表面得到单菌落。有时这种单菌落并非都由单个细胞繁殖而来的,故必须反复分离多次才可得到纯种。其原理是将微生物样品在固体培养基表面多次作“由点到线”稀释而达到分离目的的。划线的方法很多,常见的比较容易出现单个菌落的划线方法有斜线法、曲线法、方格法、放射法、四格法等。
图2 平板划线法
1.4 稀释摇管法
用固体培养基分离严格厌氧菌有特殊性,如果该微生物暴露于空气中不立即死亡,可以采用通常的方法制备平板,然后置放在封闭的容器中培养,容器中的氧气可采用化学、物理或生物的方法清除。对于那些对氧气更为敏感的厌氧性微生物,纯培养的分离则可采用稀释摇管培养法进行,它是稀释倒平板法的一种变通形式。先将一系列盛无菌琼脂培养基的试管加热使琼脂熔化后冷却并保持在50℃左右,将待分离的材料用这些试管进行梯度稀释,试管迅速摇动均匀,冷凝后,在琼脂柱表面倾倒一层灭菌液体石蜡和固体石蜡的混合物,将培养基和空气隔开。培养后,菌落形成在琼脂柱的中间。进行单菌落的挑取和移植,需先用一只灭菌针将液体石蜡--石蜡盖取出,再用一只毛细管插入琼脂和管壁之间,吹入无菌无氧气体,将琼脂柱吸出,置放在培养皿中,用无菌刀将琼脂柱切成薄片进行观察和菌落的移植。
2、用液体培养基分离和纯化
大多数细菌和真菌,用平板法分离通常是满意的,因为它们的大多数种类在固体培养基上长得很好。然而迄今为止并不是所有的微生物都能在固体培养基上生长,例如一些细胞大的细菌、许多原生动物和藻类等,这些微生物仍需要用液体培养基分离来获得纯培养。
稀释法是液体培养基分离纯化常用的方法。接种物在液体培养基中进行顺序稀释,以得到高度稀释的效果,使一支试管中分配不到一个微生物。如果经稀释后的大多数试管中没有微生物生长,那么有微生物生长的试管得到的培养物可能就是纯培养物。如果经稀释后的试管中有微生物生长的比例提高了,得到纯培养物的机率就会急剧下降。因此,采用稀释法进行液体分离,必须在同一个稀释度的许多平行试管中,大多数(一般应超过95%)表现为不生长。
3、单细胞(孢子)分离
只能分离出混杂微生物群体中占数量优势的种类是稀释法的一个重要缺点。在自然界,很多微生物在混杂群体中都是少数。这时,可以采取显微分离法从混杂群体中直接分离单个细胞或单个个体进行培养以获得纯培养,称为单细胞(或单孢子)分离法。单细胞分离法的难度与细胞或个体的大小成反比,较大的微生物如藻类、原生动物较容易,个体很小的细菌则较难。
较大的微生物,可采用毛细管提取单个个体,并在大量的灭菌培养基中转移清洗几次,除去较小微生物的污染。这项操作可在低倍显微镜,如解剖显微镜下进行。对于个体相对较小的微生物,需采用显微操作仪,在显微镜下用毛细管或显微针、钩、环等挑取单个微生物细胞或孢子以获得纯培养。在没有显微操作仪时,也可采用一些变通的方法在显微镜下进行单细胞分离,例如将经适当稀释后的样品制备成小液滴在显微镜下观察,选取只含一个细胞的液体来进行纯培养物的分离。单细胞分离法对操作技术有比较高的要求,多限于高度专业化的科学研究中采用。
4、选择培养分离
没有一种培养基或一种培养条件能够满足一切微生物生长的需要,在一定程度上所有的培养基都是选择性的。如果某种微生物的生长需要是已知的,也可以设计特定环境使之适合这种微生物的生长,因而能够从混杂的微生物群体中把这种微生物选择培养出来,尽管在混杂的微生物群体中这种微生物可能只占少数。这种通过选择培养进行微生物纯培养分离的技术称为选择培养分离,特别适用于从自然界中分离、寻找有用的微生物。自然界中,在大多数场合微生物群落是由多种微生物组成的,从中分离出所需的特定微生物是十分困难的,尤其当某一种微生物所存在的数量与其它微生物相比非常少时,单采用一般的平板稀释法几乎是不可能的。要分离这种微生物,必须根据该微生物的特点,包括营养、生理、生长条件等,采用选择培养分离的方法。或抑制使大多数微生物不能生长,或造成有利于该菌生长的环境,经过一定时间培养后使该菌在群落中的数量上升,再通过平板稀释等方法对它进行纯培养分离。
4.1 利用选择平板进行直接分离
根据待分离微生物的特点选择不同的培养条件,有多种方法可以采用。例如要分离高温菌,可在高温条件下进行培养;要分离某种抗菌素抗性菌株,可在加有抗菌素的平板上进行分离;有些微生物如螺旋体、粘细菌、蓝细菌等能在琼脂平板表面或里面滑行,可以利用它们的滑动特点进行分离纯化,因为滑行能使它们自己和其它不能移动的微生物分开。可将微生物群落点种到平板上,让微生物滑行,从滑行前沿挑取接种物接种,反复进行,得到纯培养物。
4.2 富集培养
富集培养法原理和方法非常简单,利用不同微生物间生命活动特点的不同,制定特定的环境条件,使仅适应于该条件的微生物旺盛生长,从而使其在群落中的数量大大增加,很容易地分离到所需的特定微生物。富集条件可根据所需分离的微生物的特点从物理、化学、生物、及综合多个方面进行选择,如温度、pH、紫外线、高压、光照、氧气、营养等等许多方面。在相同的培养基和培养条件下,经过多次重复移种,最后富集的菌株很容易在固体培养基上长出单菌落。如果要分离一些专性寄生菌,就必须把样品接种到相应敏感宿主细胞群体中,使其大量生长。通过多次重复移种便可以得到纯的寄生菌。
5、二元培养物
分离的目的通常是要得到纯培养。然而,在有些情况下这是很难做到的。但可用二元培养物作为纯化培养的替代物。含有二种以上微生物的培养物称为混合培养物,而如果培养物中只含有二种微生物,而且是有意识的保持二者之间的特定关系的培养物称为二元培养物。例如二元培养物是保存病毒的最有效途径,因为病毒是细胞生物的严格的细胞内寄生物。有一些具有细胞的微生物也是严格的其它生物的细胞内寄生物,或特殊的共生关系。对于这些生物,二元培养物是在实验室控制条件下可能达到的最接近于纯培养的培养方法。另外,猎食细小微生物的原生动物也很容易用二元培养法在实验室培养,培养物由原生动物和它猎食的微生物二者组成。例如,纤毛虫、变形虫和粘菌。
在以上介绍的几种方法中,平板分离法普遍用于实验室微生物的分离与纯化。微生物在固体培养基上生长形成的单个菌落,通常是由一个细胞繁殖而成的集合体。因此可通过挑取单菌落而获得一种纯培养。获取单个菌落的方法可通过稀释涂布平板或平板划线等技术完成。值得指出的是,从微生物群体中经分离生长在平板上的单个菌落并不一定保证是纯培养。因此,纯培养的确定除观察其菌落特征外,还要结合显微镜检测个体形态特征后才能确定,有些微生物的纯培养要经过一系列分离与纯化过程和多种特征鉴定才能得到。












